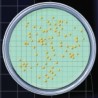
NPS pour la détection des bactéries et des moisissures dans le vin

Livré avec
50 boites de pétri avec milieux de culture stériles déshydratés sur un support en carton.
50 membranes quadrillées vertes de diamètre 50 mm et de porosité 0.45 μm
Incubation
Bactéries lactiques: 2 à 5 jours à 30°C en anaérobie
Bactéries acétiques: 2 à 5 jours à 30°C en aérobie
Croissance
La croissance des levures et des moisissures est inhibée par l'actidione (cycloheximide).